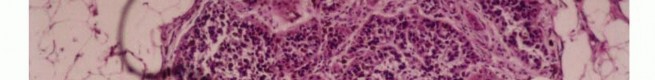
Image

Precision Biopsy of Musculoskeletal Tumors for Accurate Diagnosis

Key Takeaway
For anyone wondering about Precision Biopsy of Musculoskeletal Tumors for Accurate Diagnosis, A biopsy of musculoskeletal tissue is a fundamental and final diagnostic procedure for musculoskeletal tumors. It is crucial for determining the nature of a lesion, based on a comprehensive evaluation including clinical examination, imaging studies, and pathological findings. A poorly performed biopsy can hinder accurate diagnosis and impede safe tumor resection.
Introduction and Epidemiology
Biopsy represents a foundational and non-negotiable step in the accurate diagnosis and subsequent management of musculoskeletal tumors. In the realm of orthopedic oncology, the biopsy must be regarded as the definitive diagnostic procedure, not merely as an expedited shortcut to tissue acquisition. The diagnostic evaluation of any musculoskeletal lesion is strictly predicated on a triad of clinical, pathologic, and advanced imaging findings. All three of these critical components must coincide. If there is any discordance among the clinical presentation, radiographic signature, and histopathologic interpretation, the diagnosis must be critically questioned, and the case re-evaluated prior to any definitive surgical intervention.
From a purely mechanical standpoint, most biopsies are technically straightforward to perform. However, the cognitive decisions regarding the indication for biopsy, the specific region of the lesion to be sampled, the anatomic approach, and the biopsy technique dictate the difference between a successful diagnostic procedure and an oncologic catastrophe. A poorly planned or executed biopsy frequently becomes an insurmountable obstacle to proper diagnosis and may severely impede the performance of an adequate, safe, and limb-salvaging tumor resection.



Historically, biopsies executed in referring institutions rather than specialized orthopedic oncology centers have been associated with unacceptably high rates of devastating complications. Landmark multi-institutional studies by Mankin et al., under the auspices of the Musculoskeletal Tumor Society (MSTS), demonstrated that biopsies performed outside of treating oncology centers resulted in a high incidence of major errors in diagnosis (up to 18%), non-representative sampling, and local complications that ultimately led to unnecessary amputations or compromised patient survival. Consequently, the current standard of care dictates that the orthopedic oncologist who will perform the definitive resection should either perform the biopsy or directly dictate its anatomic approach and execution.



Epidemiologically, primary malignant bone and soft tissue tumors (sarcomas) are exceptionally rare, comprising less than 1% of all adult malignancies and approximately 15% of pediatric malignancies. The rarity of these lesions directly contributes to the frequency of mismanagement in non-specialized centers, where practitioners may only encounter one or two true sarcomas in a decade of practice. Conversely, benign musculoskeletal tumors are significantly more common, but their clinical and radiographic presentation can often mimic malignant pathology, necessitating a rigorous, standardized, and protocol-driven approach to every unknown musculoskeletal mass.
Surgical Anatomy and Biomechanics
Tumors arising in bone and soft tissues share characteristic patterns of biologic behavior, stemming from their common mesenchymal origin and shared anatomic environment. These unique growth patterns form the foundational basis of the Enneking surgical staging system and dictate all current surgical treatment strategies.
Histologically, sarcomas are categorized as low, intermediate, or high grade based on tumor morphology, cellularity, extent of pleomorphism, nuclear atypia, mitotic rate, and the presence of spontaneous necrosis. Histologic grading represents the biologic aggressiveness of the tumor and correlates directly with the likelihood of distant metastasis and local recurrence.



Sarcoma Growth Patterns and the Pseudocapsule
Sarcomas typically form a solid, expansile mass that grows centrifugally. Due to this centrifugal growth pattern, the periphery of the lesion is the least mature, most cellular, and most biologically active region, making it the ideal target for biopsy sampling. Unlike the true capsule that surrounds benign lesions—which is composed of compressed normal cells and mature fibrous tissue—sarcomas are generally enclosed by a reactive zone commonly referred to as a "pseudocapsule."
This pseudocapsule consists of compressed tumor cells, a fibrovascular zone of reactive tissue, and a variable inflammatory component that interacts with the surrounding normal tissues. Crucially, the pseudocapsule is not a true anatomic barrier. Microscopic tumor extensions, known as satellite lesions, frequently penetrate this reactive zone and reside in the immediately adjacent normal-appearing tissue. Therefore, a biopsy that breaches the pseudocapsule inevitably contaminates the surrounding tissue planes with malignant cells.



Compartmental Anatomy and Skip Metastases
The concept of compartmental anatomy is paramount in orthopedic oncology. A compartment is defined as an anatomic space bounded by natural barriers to tumor extension, such as major fascial septa, cortical bone, articular cartilage, and dense tendinous insertions. Tumors confined entirely within a single compartment (intracompartmental, Enneking Stage T1) have a significantly better prognosis and require less morbid resections than those extending beyond these boundaries into adjacent spaces (extracompartmental, Enneking Stage T2).
Furthermore, aggressive high-grade sarcomas may shed cells that break through the pseudocapsule and travel along longitudinal tissue planes to form metastases within the same anatomic compartment, entirely separate from the primary mass. These are termed "skip metastases." By definition, these are locoregional micrometastases that have not passed through the systemic circulation.



The biopsy tract itself creates an iatrogenic communication between the tumor and the external environment, effectively contaminating every anatomic layer it traverses. Because this tract must be excised en bloc with the tumor during definitive surgery, the anatomic placement of the biopsy is as critical as the resection itself. Misplacement of a biopsy tract can convert an intracompartmental lesion into an extracompartmental one, drastically altering the surgical options.
Indications and Contraindications
The decision to biopsy a musculoskeletal lesion requires careful consideration of the differential diagnosis generated by clinical and radiographic evaluation. It is imperative to recognize that not all lesions require a biopsy. "Leave me alone" lesions, such as non-ossifying fibromas (NOF), simple bone cysts, asymptomatic enchondromas, classic osteochondromas, and typical hemangiomas, can often be diagnosed definitively on imaging alone. Biopsying these lesions exposes the patient to unnecessary surgical risk and can occasionally lead to confusing histopathologic interpretations due to reactive changes.



When a biopsy is definitively indicated, the surgeon must choose between a core needle biopsy (CNB), an open incisional biopsy, or an excisional biopsy. CNB is currently the gold standard for the majority of bone and soft tissue tumors due to its high diagnostic yield (frequently >90% in experienced centers), minimal tissue contamination, and low complication rate when performed under image guidance.
| Modality | Primary Indications | Contraindications |
|---|---|---|
| Observation | Asymptomatic latent benign lesions (e.g., NOF, classic hemangioma, fibrous dysplasia). | Painful, growing, or destructive lesions; indeterminate imaging characteristics. |
| Core Needle Biopsy (CNB) | Suspected primary sarcoma, metastatic carcinoma, deep soft tissue masses. Preferred initial modality. | Inaccessible anatomic locations (rare with modern CT guidance), severe uncorrectable coagulopathy. |
| Open Incisional Biopsy | Non-diagnostic CNB; necessity for large tissue volume for complex molecular profiling/cytogenetics. | Poorly planned approach that compromises future limb salvage; lack of complete preoperative imaging. |
| Excisional Biopsy | Small (< 3-5 cm), superficial soft tissue masses presumed to be benign (e.g., lipoma, epidermal inclusion cyst). | Suspected sarcoma; deep intra-muscular lesions; lesions > 5 cm. |



Absolute contraindications to any biopsy include incomplete local and systemic staging. A biopsy should never be performed before advanced imaging (MRI of the entire compartment) is obtained. Post-biopsy hemorrhage, hematoma formation, and peritumoral edema will obscure the true anatomic extent of the tumor on subsequent imaging, severely complicating surgical planning and potentially leading to inadequate resection margins.
Pre Operative Planning and Patient Positioning
Preoperative planning for a musculoskeletal tumor biopsy must be as rigorous and detailed as planning for a major joint arthroplasty or complex pelvic fracture fixation. The fundamental, unbreakable rule of orthopedic oncology is that the biopsy tract must be placed in a location that allows for its complete excision en bloc with the definitive tumor specimen.
Imaging and Staging
Prior to any tissue sampling, complete local and systemic imaging must be obtained. This typically includes high-quality orthogonal plain radiographs of the affected bone, and a contrast-enhanced MRI of the entire anatomic compartment (joint-to-joint) to assess tumor volume, neurovascular proximity, and the presence of skip metastases. Staging studies, including a CT of the chest to rule out pulmonary metastases, and potentially a whole-body bone scan or PET-CT, should be completed or scheduled prior to the biopsy.



Multidisciplinary Review
Modern orthopedic oncology relies heavily on a multidisciplinary approach. The clinical presentation, radiographic features, and anticipated pathologic findings should be discussed in a multidisciplinary tumor board (MDT) setting involving orthopedic oncologists, musculoskeletal radiologists, specialized sarcoma pathologists, and medical/radiation oncologists prior to the biopsy. This ensures that sufficient tissue is obtained for all necessary modern ancillary studies, including flow cytometry, cytogenetics, and molecular profiling.



Patient Positioning and Tourniquet Use
Patient positioning must facilitate not only the biopsy but also the anticipated definitive surgical approach. The limb should be positioned exactly as it would be for the final resection to ensure the skin incision and underlying tract align properly when the patient is re-positioned for the definitive surgery.
If a tourniquet is utilized during an open biopsy to improve visualization, the limb must be exsanguinated by gravity elevation alone for 3 to 5 minutes. The use of an Esmarch bandage is strictly contraindicated, as the mechanical compression can theoretically force tumor cells into the systemic venous circulation, potentially inducing iatrogenic metastasis. The tourniquet should be deflated prior to closure to ensure absolute hemostasis, as postoperative hematoma formation will massively expand the zone of contamination.



Detailed Surgical Approach and Technique
The technical execution of the biopsy is governed by strict oncologic principles. Adherence to these principles minimizes the risk of local recurrence and maximizes the potential for limb-sparing surgery.
Core Needle Biopsy Technique
When performing a CNB, image guidance (ultrasound for superficial soft tissues or CT for deep/intraosseous lesions) is highly recommended to ensure the most biologically active portion of the tumor is sampled, deliberately avoiding areas of central necrosis.
1. Incision: A 2-3 mm stab incision is made in the skin.
2. Trajectory: The needle trajectory must traverse the absolute minimum amount of normal tissue necessary. It must not cross multiple anatomic compartments, joint spaces, or contaminate major neurovascular bundles.
3. Sampling: A coaxial needle system (e.g., 11-gauge introducer with a 13-gauge cutting needle) is preferred. The outer cannula remains in place, protecting the tract from seeding, while the inner cutting needle is deployed multiple times to obtain several cylindrical cores of tissue.
4. Tract Tattooing: The entry site is often marked with a small dot of India ink or a localizing suture to ensure the exact tract is identified and excised during definitive surgery.

Open Incisional Biopsy Technique
If an open biopsy is required due to non-diagnostic CNB or the need for substantial tissue architecture, the following meticulous steps must be followed:
- Incision Orientation: The incision must be strictly longitudinal. Transverse incisions contaminate a wider swath of skin and subcutaneous tissue, making subsequent en bloc elliptical excision exceedingly difficult or impossible without massive soft tissue defects that require complex flap coverage.
- Dissection: Dissection must proceed directly to the tumor through the underlying muscle. Internervous and intermuscular planes should generally be avoided. While these planes are utilized in standard orthopedic trauma to preserve function, in oncology, contaminating a fascial plane between two muscles necessitates the resection of both muscles. Dissecting directly through the belly of a single muscle confines the contamination to that single muscle.
- Tissue Handling: Flaps must not be elevated. Retraction should be minimal to avoid spreading tumor cells into adjacent planes.
- Cortical Window: If the lesion is intraosseous, a cortical window may be necessary. This window should be oval or round; square corners create stress risers that significantly increase the risk of a postoperative pathologic fracture.
- Sampling: The sample must be taken from the periphery of the tumor (the most viable tissue), avoiding the necrotic center. Frozen section should be utilized to confirm that diagnostic tissue (not just necrotic debris) has been obtained.
- Defect Management: Following sampling, the cortical defect must be meticulously plugged. Polymethylmethacrylate (PMMA) bone cement, Gelfoam, or bone wax is packed into the defect to prevent the egress of tumor cells and marrow hematoma into the surrounding soft tissues.
- Hemostasis and Closure: Absolute hemostasis is mandatory. A postoperative hematoma is considered entirely contaminated with tumor cells; a large hematoma
Clinical & Radiographic Imaging









You Might Also Like